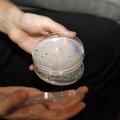

EL ANUNCIANTE
DE INTERÉS
III Congreso de Gastronomía & Vino en Castellón
Volver a Noticia III Congreso de Gastronomía & Vino en Castellón
© 2026 vivecastellon.com | Noticias Castellón | C/ La Olivera, 5 - portal 1 - 1B - 12005 Castellón | Tel. 609 605 564 - 650 977 277 | AVISO LEGAL | portada | Nuestros anunciantes